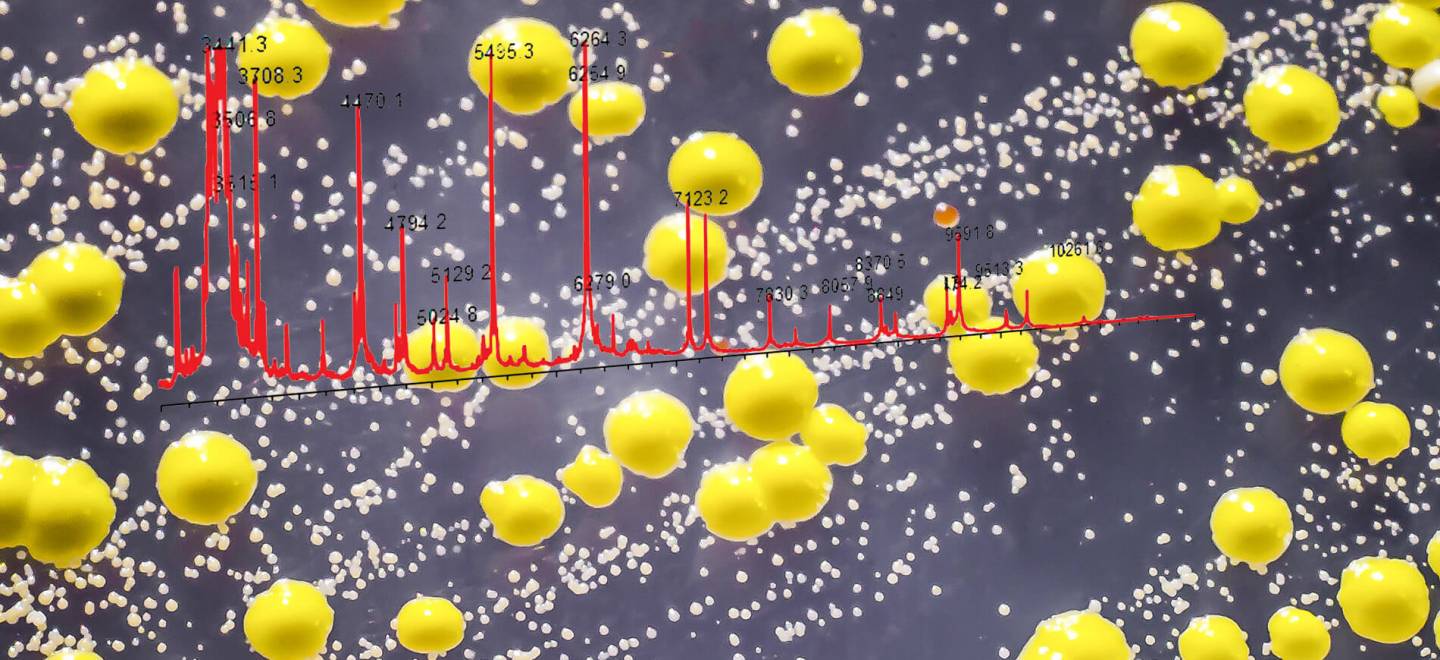

IDENTIFICAÇÃO PRECISA DE MICRORGANISMOS NO AMBIENTE FARMACÊUTICO por Espectometria de Massa MALDI-TOF
Quando a qualidade da base de dados faz toda a diferença!
A contaminação microbiológica de produtos farmacêuticos é um grande problema no processo de produção de produtos farmacêuticos, tanto do ponto de vista da segurança como do financeiro. A identificação rápida e precisa de microrganismos pode contribuir para reduzir custos e o tempo gasto em investigações e ações corretivas. É evidente que tanto os produtos farmacêuticos estéreis como os não-estéreis devem estar livres de microrganismos nocivos. Além disso, o impacto financeiro da contaminação no processo de produção pode ser significativo; desde a destruição de grandes quantidades de produtos finais de grande valor chegando até a todos os custos e danos da marca associados a um recall.
IDENTIFICAÇÃO DE MICRORGANISMOS NO AMBIENTE FARMACÊUTICO: FUNDAMENTAL PARA A QUALIDADE
A importância da identificação microbiana tem sido ressaltada pelas autoridades, como, por exemplo, se ve no novo Anexo 1 (Versão 12) das BPF da UE para a Produção de Produtos Estéreis estipula que, em tradução livre:
"9.31 Os microrganismos detectados nas áreas de Grau A e Grau B devem ser identificados a nível de espécie e devem ser avaliados seu potencial impacto na qualidade do produto (para cada lote implicado), além do estado geral de controle. Deve também ser considerada a identificação de microrganismos detectados em áreas de Graus C e D (por exemplo, quando os níveis de ação ou de alerta sejam excedidos ou quando microrganismos atípicos ou potencialmente indefensáveis sejam recuperados). A abordagem para identificação e investigação do organismo deve ser documentada.”
A orientação para a indústria publicada pelo FDA (Medicamentos Estéreis Produzidos por Processamento Asséptico - Boas Práticas de Fabricação Atual), especifica que (tradução livre) a "caracterização de microrganismos recuperados fornece informação vital para o programa de monitoramento ambiental. Os isolamentos ambientais estão frequentemente correlacionados com os contaminantes encontrados no media fill ou na falha em testes de esterilidade do produto, e o quadro global do ambiente fornece informações valiosas para uma investigação".
A Farmacopeia dos EUA (USP) Capítulo <1116< sobre controle microbiológico e monitoramento de ambientes de processamento asséptico também declara que - em tradução livre: “um programa de monitoramento ambiental bem sucedido inclui um nível adequado de microbiota obtida por amostragem. O conhecimento da microbiota nos ambientes controlados ajuda a determinar o perfil microbiológico habitual esperado para a fábrica e avaliar a eficácia dos procedimentos de limpeza e sanitização, bem como de métodos e procedimentos de coleta. A informação obtida de um programa de identificação pode ser útil na investigação da fonte de contaminação, especialmente se a frequência de detecção recomendada for ultrapassada. A identificação de isolados de áreas críticas e adjacentes é mais importante do que a identificação de micro-organismos de áreas não críticas. Os métodos de identificação devem ser verificados e kits prontos para uso devem estar qualificados para o fim a que se destinam".
O monitoramento do ambiente crítico e dos arredores de áreas limpas, bem como o monitoramento de pessoal, devem incluir a identificação rotineira de micro-organismos a nível de espécie (ou, quando apropriado, do gênero).
A identificação microbiana é, portanto, de primordial importância no controle da área produtiva e do processo. Em alguns casos, os dados de tendências ambientais revelaram a migração de microrganismos de áreas não controladas ou menos controladas para a sala de processamento asséptico.